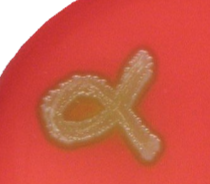
<p>A(n) ________ hemolysis test shows the <strong>partial</strong> breakdown of red blood cells. </p>
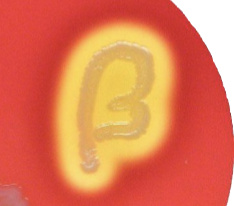
<p>A(n) __________ hemolysis test shows the <strong>complete</strong> breakdown of red blood cells. </p>
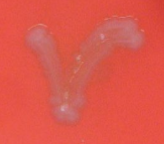
<p>A(n) ________ hemolysis test shows <strong>no </strong>breakdown of red blood cells. </p>
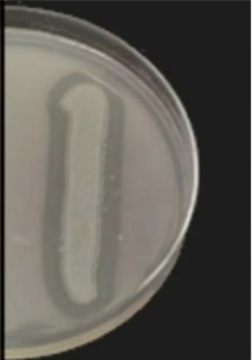
<p>This is a ______ DNase test.</p>

1/75
Looks like no tags are added yet.
Name | Mastery | Learn | Test | Matching | Spaced | Call with Kai |
|---|
No analytics yet
Send a link to your students to track their progress
Triple Sugar Iron (TSI)
What differential test differentiates enteric bacteria based on the ability to reduce sulfur and ferment carbohydrates? It contains glucose, sucrose, a small amount of glucose, ferrous sulfate, and a pH indicator (phenol red)

Sulfur, Carbohydrates
The Triple Sugar Iron test differentiates bacteria based on the ability to reduce _______ and ferment _________.
Did not
A TSI test that is this color means that the bacteria _______ ferment (did or did not?)

Glucose only
A TSI test that is this color means that the bacteria fermented _________ ONLY.

Sulfur
A TSI test that is this color means that the bacteria reduced _________ to hydrogen sulfide.

Sucrose, lactose
A TSI test that is this color means that the bacteria fermented ________ and/or ________. We can tell this by the tube being yellow throughout with cracks in the agar from CO2 gas being produced.

Hydrogen Sulfide, Sucrose, Lactose
A TSI test that is this color means that there was ________ _______ produced, _________ OR _________ are fermented.

Hydrogen sulfide, Iron sulfide
In a TSI test, sulfur gets reduced to _____________ which reacts with iron to form ____________, a black precipitate.
Selective, Differential
An Eosin Methylene Blue (EMB) Agar plate is both _______ and _______, meaning that it differentiates gram negative bacteria based on how they ferment lactose.
Eosin Methylene Blue (EMB)
What test differentiates gram negative bacteria based on how they ferment lactose?
Gram Negative
What type of bacteria does an EMB plate differentiate?
Non
A ________ lactose fermenter will present with a colorless, off-white or light pink colonies on an EMB plate. This means that the pH was not affected.
Slow
A _________ lactose fermenter will present with pink colonies, meaning that the pH was slightly altered.
Good
A _________ lactose fermenter will present with dark purple colonies, meaning that there are more acids produced which lowers the pH and stimulates dye absoprtion by colonies.
Strong
A __________ lactose fermenter will present with metallic green sheen on the surface of the colonies. The pH has been strongly altered.
Differential
An Indole production Test is a ________ test used to determine the ability of bacteria to produce indole from the amino acid tryptophan. The presence of indole is detected by the addition of Kovacs reagent.

Indole Test
What type of test is used to determine the ability of bacteria to produce indole from the amino acid tryptophan?
Kovacs
We add ________ reagent (10 drops) to an indole production test to determine the presence of indole
Positive
This indole test is _______.

Negative
This indole test is ________

Durham Fermentation (Carbohydrates Fermentation)
What test tests the ability of bacteria to ferment different types of sugars to produce organic acids and/or alcohol, CO2?

Positive
A color change from green to yellow in a Durham Fermentation test means that the bacteria has fermented sugar. Is this a positive or negative result?

Air bubble, CO2
A Durham Fermentation test tube that has an ______ ________ in it means that there was production of _______ during fermentation.
Citrate Utilization Test
What test is used to differentiate enterics based on their ability to utilize citrate as a sole source of carbon and ammonium ions as a sole nitrogen source?

Green
A negative citrate utilization test will be what color?
Blue
A positive citrate utilization test will be what color?
Citrate, Ammonium Ions
A Citrate Utilization Test is used to differentiate enterics based on their ability to utilize _______ as a sole source of carbon and __________ _____ as sole nitrogen source.
Differential
The Citrate utilization test is a _______ medium.
Vogues-Proksauer Test
What differential test is used to determine the ability of bacteria to ferment glucose via the butanediol pathway?

Glucose, Butanediol
A Vogues Proskauer Test is used to determine the ability of bacteria to ferment _______ through the ________ pathway
The Butanediol Pathway:
Glucose → 2 Pyruvate → alpha-acetolactate → acetoin → 2,3 butanediol
Positive, Glucose
This Vogues-Proskauer Test is ________ (positive or negative) and means that _______ was fermented via a butanediol pathway.

Negative
This Vogues-Proskauer Test is __________.

Urease Test
What test differentiates bacteria based on their ability to break down urea using the enzyme urease? The pH indicator is phenol red, and the accumulation of ammonia in the medium turns it alkaline.
Pink
A positive Urease Test will be what color?
Urease
The Urease Test differentiates bacteria based on their ability to break down _______.
Differential
The Urease Test is a _________ test.
Exoenzymes
Enzymes that are synthesized within the cell, but exported across the membrane to hydrolyze compounds in the periplasmic space or extracellular environment.
Starch
A branched polymer made up of glucose monomers. It is a primary nutrient storage molecule in plants
Amylase
An exoenzyme that hydrolyzes starch to release glucose monomers
Lipids
Complex polymers up of glycerol and fatty acid monomers
Lecithinase
An exoenzyme that hydrolyzes the phospholipid lecithin into its constituent parts.
Proteins
Polymers of amino acid monomers. Serve a wide variety of biological functions
Proteases
An exoenzyme that hydrolyzes proteins into smaller peptide fragments or amino acids, which are readily absorbed by the cell
Casein
A major protein found in dairy products.
Alpha
A(n) ________ hemolysis test shows the partial breakdown of red blood cells.
Beta
A(n) __________ hemolysis test shows the complete breakdown of red blood cells.
Gamma
A(n) ________ hemolysis test shows no breakdown of red blood cells.
Streptolysin O
What Streptolysin enzyme is inactivated by oxygen?
Streptolysin S
What Streptolysin enzyme is an oxygen stable enzyme?
Enriched, Differential
A Hemolysis activity test is both _________ and _________ based on blood enhanced growth for fastidious bacteria and based on hemolysis, respectively.
Tellurite-Glycine Agar (TGA)
What test differentiates between bacteria’s ability to clot blood plasma?
Mannitol, Tellurite
A Tellurite-Glycine Agar Test can be used to test whether or not a bacteria can ferment ________, and reduce _________.
Black
Bacteria that can ferment mannitol and reduce tellurite will appear what color on TGA plates?
O2
What gas is produced during a positive catalase test?
Catalase Test
What test identifed if bacteria can produce the exoenzyme catalase?
Catalase
An exoenzyme that breaks H2O2 and protects the cell from toxic forms of oxygen
H2O2
What do we add to a catalase test?
DNase Test
What test identifies if bacteria is able to produce the exoenzyme DNase?
HCl
What do we add to a DNase test to check the activity?
Positive
This is a ______ DNase test.
Bile Esculin Test
What test differentiates bile-resistant organisms based on their ability or inability to hydrolyze esculin?
Differential, Selective
A Bile Esculin Test is both ________ and ________.
Esculetin
What binds to iron in a Bile Esculin Test to produce a black precipitate?
Bubbles, catalase
If _______ appear after adding 3% H2O2 to a catalase plate, it means that ______ is present.
Resistance
If a bacteria grows on a Bile Esculin test, it is safe to assume that it has a bile _______.
Brown
If the streak on a Bile Esculin test is ______ or black, it means it is positive for Esculin hydroloysis.
Disinfection
The killing/removal of bacteria from surfaces.
Typically through the use of chemical-based disinfectants.
Does not remove all bacteria/microbes.
Does not remove spores.
Sterilization
Kills all living cells, both vegetative cells and spores. Typically achieved using chemicals, UV radiation, or high heat/steam
Pasteurization
The partial sterilization of food products to make them suitable for consumption. Typically achieved using extreme hot/cold or filtration
Bacteriostatic
Inhibits bacterial growth but does not kill the organism.
Bactericidal
Kills bacteria
Pasteurization, Boiling, Autoclaving
What 3 methods of sterilization that use excessive heat to denature proteins and kill contaminating microbes?
Denature, Disrupt
Most disinfectants _______ proteins or ________ membrane function
Triclosan
Chlorinated aromatic compound with antifungal and antibacterial activity
Phenol
Aromatic, organic compound first utilized as a disinfectant in 1867.
Pyrimidine Dimers
What forms when DNA is exposed to UV light? IT can result in helical distortion, mutagenesis, and disease.